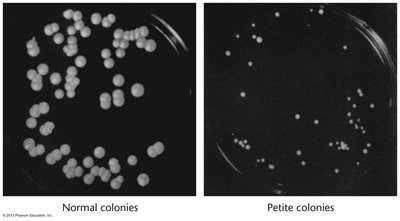
Normal and petite yeast colonies

Back
BackExtranuclear Inheritance: Organelle, Infectious, and Maternal Effects
Study Guide - Smart Notes

Extranuclear Inheritance
Introduction to Extranuclear Inheritance
Extranuclear inheritance refers to the transmission of genetic material that is not located within the nucleus. This form of inheritance can significantly influence an organism's phenotype and is often distinct from classical Mendelian inheritance. The main sources of extranuclear genetic material include organelle genomes, infectious agents, and maternal gene products.
Nuclear genome: The primary source of genetic material, but not the only one affecting phenotype.
Cytoplasmic inheritance: Genetic information is transmitted through the cytoplasm, often from only one parent (typically the mother).
Types of Extranuclear Inheritance
Extranuclear inheritance can be classified into three main types:
Organelle (maternal) heredity: Involves DNA from mitochondria or chloroplasts.
Infectious heredity: Results from symbiotic or parasitic microorganisms affecting host phenotype.
Maternal effects: Maternal gene products in the egg cytoplasm influence offspring phenotype.
Organelle (Maternal) Heredity
Organelle Genomes and Maternal Inheritance
Organelle heredity involves the transmission of genetic material from mitochondria and chloroplasts, which possess their own genomes separate from the nuclear genome. These organelles are usually inherited only from the maternal parent, leading to unique patterns of inheritance.
Mitochondria: Present in both plants and animals, contain their own DNA.
Chloroplasts: Found in plants, also contain their own DNA.
Each cell contains multiple copies of these organelles, typically inherited maternally.


Clonal and Heteroplasmic Organelle Genomes
Clonal organelle genome: Usually only one type of organelle genome is present.
Heteroplasmy: Occurs when more than one clonal line of organelle genomes exists within a cell.

Chloroplast Inheritance: Variegation in Plants
Variegation in Japanese Four o'clock plants is a classic example of chloroplast inheritance.
White leaves: Result from a shortage of chlorophyll.
Offspring display the phenotype only if the maternal plant expresses it.


Chloroplast Inheritance: Antibiotic Resistance in Chlamydomonas
Reciprocal crosses demonstrate uniparental inheritance of non-chromosomal genes (e.g., streptomycin resistance).
Nuclear genes segregate, but organelle genes do not.

Mitochondrial Inheritance: Petite Yeast
Petite yeast mutants illustrate mitochondrial inheritance.
Petite colonies: Result from mutations in mitochondrial DNA.
Inheritance patterns can be Mendelian or non-Mendelian, depending on the type of petite.

Mitochondrial Disorders in Humans
Mitochondrial disorders are inherited maternally and often involve deficiencies in bioenergetic function due to mutations in mitochondrial genes.
Examples include disorders affecting the heart, eye, liver, kidney, pancreas, blood, inner ear, colon, brain, and skeletal muscle.
Inheritance is strictly maternal, as sperm contribute virtually no mitochondria to the zygote.



Endosymbiosis Theory
The endosymbiosis theory explains the origin of mitochondria and chloroplasts as descendants of ancient symbiotic bacteria.
Mitochondria originated from endosymbiotic purple bacteria.
Chloroplasts originated from endosymbiotic cyanobacteria.

Infectious Heredity
Microorganisms and Host Phenotype
Infectious heredity occurs when a symbiotic or parasitic microorganism alters the host's phenotype and is transmitted to offspring.
Transmission occurs via the maternal egg cytoplasm.
Examples include viruses and protozoans affecting Drosophila.

Examples of Infectious Heredity
Rhabdovirus Sigma in Drosophila: Causes CO2 sensitivity; affected flies do not recover normally from CO2 anesthesia.
Protozoan in Drosophila: Affected flies produce predominantly female offspring at lower temperatures; injection of ooplasm or protozoan into normal oocytes induces altered sex ratio.

Maternal Effects on Phenotype
Maternal Genotype and Embryonic Development
Maternal effects refer to the influence of the maternal genotype on the phenotype of the offspring, often through gene products stored in the egg cytoplasm.
mRNA transcripts in the egg initiate metabolism in the newly formed individual before the new genome is used.
Sperm contributes virtually nothing to the cytoplasm of the zygote.


Permanent and Non-Permanent Maternal Effects
Non-permanent effect: Temporary influence, such as eye pigment in flour moth.
Permanent effect: Lasting influence, such as shell coiling in Limnaea.



Shell Coiling in Limnaea
The direction of shell coiling in Limnaea is determined by a maternal developmental gene that controls spindle orientation during the second mitotic division of the zygote.
Dextral (right-handed) and sinistral (left-handed) coiling are inherited based on the mother's genotype.



Summary Table: Types of Extranuclear Inheritance
Type | Source | Inheritance Pattern | Example |
|---|---|---|---|
Organelle heredity | Mitochondria, Chloroplasts | Maternal | Variegation in plants, Petite yeast, Mitochondrial disorders |
Infectious heredity | Microorganisms | Maternal (via cytoplasm) | Rhabdovirus Sigma in Drosophila, Protozoan-induced sex ratio |
Maternal effects | Maternal gene products | Maternal | Shell coiling in Limnaea, Eye pigment in flour moth |
Key Equations and Concepts
Heteroplasmy
Maternal Effect Phenotype
Endosymbiosis Theory
Conclusion
Extranuclear inheritance encompasses a variety of mechanisms by which genetic material outside the nucleus influences phenotype. Understanding these mechanisms is essential for comprehending non-Mendelian inheritance patterns and their implications in genetics, development, and disease. Additional info: Expanded explanations and context were added to ensure completeness and academic quality.
